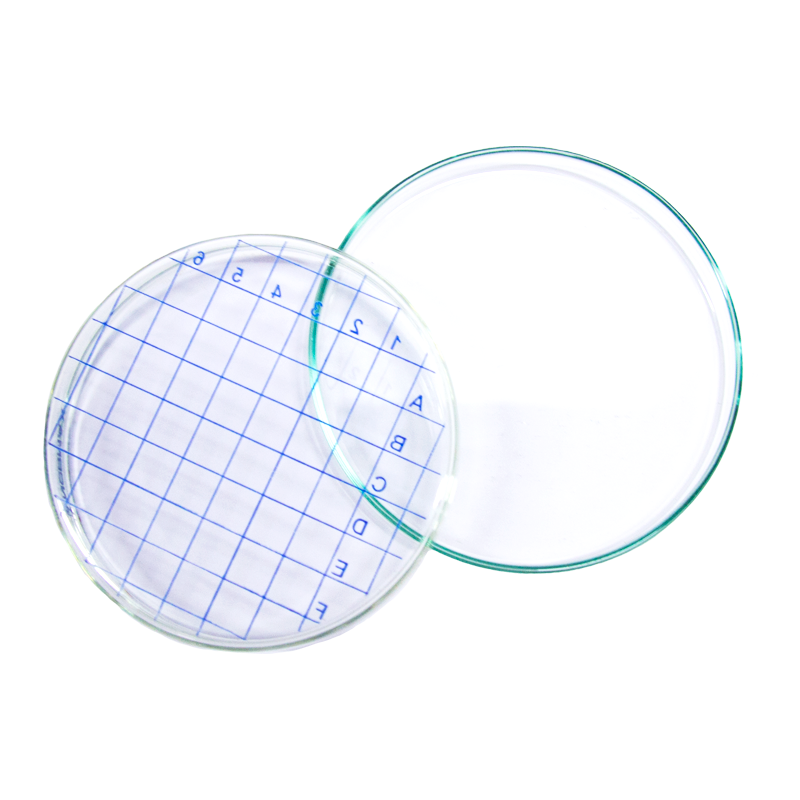

Высота чашки петри
Тест тест на знание проекта
Колеса с подъемным механизмом
Qr код входа с компьютера
Dying light водоросли
Доверительный интервал для коэффициента корреляции
Тормозные диски new actyon
Понятие индивидуальные особенности
Жд станция гороховец
Фитинги пневматические цанговые пластиковые
Социальные сети бывают
Дом престарелых в дзержинском
Схема на английском языке перевод
Как избавиться от муравьев в песочнице
Высота чашки петри 113 фотографий